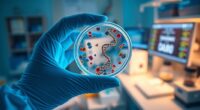
customized health treatment plans

If you’re looking for the best Japanese knife sets for 2026, I’ve found some incredible options chefs rave about. These sets feature high-quality steels like VG-10 and Damascus construction, with sharp, durable blades and ergonomic handles that make prep a breeze. They also come with stylish storage options, ensuring your knives stay in top shape. Keep going to discover the top picks and what makes each set stand out for professional and home use.
Key Takeaways
- Top-rated Japanese knife sets feature high-quality steels like VG-10, AUS-8, and Damascus for exceptional sharpness and durability.
- Reputable brands offer comprehensive sets with essential knives, stylish storage, and premium craftsmanship.
- Sets emphasize ergonomic handles and full tang construction for comfort, balance, and safety during extended use.
- Many include helpful accessories like sharpeners, shears, and storage solutions to enhance functionality and maintenance.
- Expert reviews highlight long-lasting edge retention, corrosion resistance, and superior performance in professional and home kitchens.
| Brewin CHEFILOSOPHI 5-Piece Japanese Chef Knife Set |  | Best Overall | Blade Material: German 1.4116 stainless steel | Cutting Edge Angle: 15° | Number of Pieces: 5 pieces | VIEW LATEST PRICE | See Our Full Breakdown |
| HOSHANHO 6-Piece Magnetic Knife Set with Holder |  | Best Value | Blade Material: Japanese 10Cr15CoMoV high carbon stainless steel | Cutting Edge Angle: 15° | Number of Pieces: 6 pieces | VIEW LATEST PRICE | See Our Full Breakdown |
| HOSHANHO 16-Piece Japanese Kitchen Knife Set |  | Most Comprehensive | Blade Material: Japanese 10Cr15CoMoV stainless steel | Cutting Edge Angle: 15° | Number of Pieces: 16 pieces | VIEW LATEST PRICE | See Our Full Breakdown |
| Huusk 3-Piece Japanese Butcher Knife Set |  | Top Performance | Blade Material: Japanese steel with high-quality forging | Cutting Edge Angle: 16° | Number of Pieces: 3 pieces | VIEW LATEST PRICE | See Our Full Breakdown |
| FULLHI 14-Piece Japanese German Stainless Steel Knife Set |  | Best for Professional Chefs | Blade Material: German 5Cr17 high-carbon stainless steel | Cutting Edge Angle: 16° | Number of Pieces: 14 pieces + accessories | VIEW LATEST PRICE | See Our Full Breakdown |
| Yatoshi Magnetic Japanese Knife Block Set (6 Pieces) |  | Best for Home Cooks | Blade Material: VG-10 Damascus cladding over steel core | Cutting Edge Angle: 16° | Number of Pieces: 6 pieces | VIEW LATEST PRICE | See Our Full Breakdown |
| Jikko 9-Piece Magnetic Japanese Knife Set |  | Versatile Set | Blade Material: AUS-8 Japanese steel with titanium finish | Cutting Edge Angle: 15° | Number of Pieces: 9 pieces + magnetic block | VIEW LATEST PRICE | See Our Full Breakdown |
| SHAN ZU 7-Piece Japanese Knife Set with Block |  | Stylish & Practical | Blade Material: 10Cr15MOV Japanese stainless steel | Cutting Edge Angle: 15° | Number of Pieces: 7 pieces + sharpener | VIEW LATEST PRICE | See Our Full Breakdown |
| 14-Piece Chef Knife Set with Roll Bag |  | Outdoor & Travel Ready | Blade Material: Japanese high-carbon stainless steel | Cutting Edge Angle: 15° | Number of Pieces: 14 pieces + roll bag | VIEW LATEST PRICE | See Our Full Breakdown |
| HOSHANHO 3-Piece High Carbon Steel Kitchen Knife Set |  | Heavy-Duty Performance | Blade Material: 10Cr15CoMoV high carbon stainless steel | Cutting Edge Angle: 15° | Number of Pieces: 3 pieces | VIEW LATEST PRICE | See Our Full Breakdown |
| HOSHANHO 7-Piece Japanese Kitchen Knife Set |  | Space-Saving Design | Blade Material: 10Cr15CoMoV high-carbon stainless steel | Cutting Edge Angle: 15° | Number of Pieces: 7 pieces + magnetic holder | VIEW LATEST PRICE | See Our Full Breakdown |
| MITSUMOTO SAKARI 4-Piece Japanese Chef’s Knife Set |  | Premium Craftsmanship | Blade Material: 9CR18MOV high carbon steel | Cutting Edge Angle: 15° | Number of Pieces: 4 pieces + box | VIEW LATEST PRICE | See Our Full Breakdown |
| HOSHANHO 8-Piece Japanese Chef Knife Set with Block |  | Beginner-Friendly | Blade Material: 10Cr15CoMoV Japanese steel | Cutting Edge Angle: 15° | Number of Pieces: 8 pieces + block | VIEW LATEST PRICE | See Our Full Breakdown |
| SHAN ZU 16-Piece Japanese Kitchen Knife Set |  | Durable & Long-Lasting | Blade Material: 10Cr15CoMoV Japanese steel | Cutting Edge Angle: 15° | Number of Pieces: 16 pieces + scissors/sharpener | VIEW LATEST PRICE | See Our Full Breakdown |
| SHAN ZU 16-Piece Japanese Kitchen Knife Set |  | Cutting-Edge Technology | Blade Material: Powder metallurgy steel with 63 HRC | Cutting Edge Angle: 12° | Number of Pieces: 8+ knives + accessories | VIEW LATEST PRICE | See Our Full Breakdown |
More Details on Our Top Picks
-

HOSHANHO Knife Set with Magnetic Knife Holder, 6 Pieces Japanese High Carbon Stainless Steel Kitchen Knife Sets, Ultra Sharp Professional Chef Knives Sets
【Professional Knife Set】The HOSHANHO 6 piece kitchen knife set includes all the knives you need for cooking: 8"...
As an affiliate, we earn on qualifying purchases.
Brewin CHEFILOSOPHI 5-Piece Japanese Chef Knife Set
If you’re looking for a high-quality knife set that balances professional performance with elegant design, the Brewin CHEFILOSOPHI 5-Piece Japanese Chef Knife Set is an excellent choice. I love how it combines cutting-edge technology with a sleek aesthetic, featuring handles made from luxurious pakkawood with natural texture. The knives are forged from a single piece of ultra-tough German stainless steel, giving them exceptional durability and corrosion resistance. Their razor-sharp blades deliver precise cuts, perfect for both professional chefs and home cooks. With a complete set that includes versatile knives, it’s practical, reliable, and beautifully crafted—truly a standout in any kitchen.
- Blade Material:German 1.4116 stainless steel
- Cutting Edge Angle:15°
- Number of Pieces:5 pieces
- Handle Material:Pakkawood
- Storage Type:Gift box
- Special Features:Premium craftsmanship, balanced handles
- Additional Feature:Luxurious pakkawood handles
- Additional Feature:Forged from single steel piece
- Additional Feature:Elegant gift box packaging
-

HOSHANHO 16-Piece Knife Set, Japanese High Carbon Stainless Steel Kitchen Knife Set, Ultra Sharp Chef Knife Block Set with Sharpener
【Professional Knife Set】16 piece kitchen knife set includes: 8" chef knife, 8" bread knife, 8" carving knife, 7"...
As an affiliate, we earn on qualifying purchases.
HOSHANHO 6-Piece Magnetic Knife Set with Holder
The HOSHANHO 6-Piece Magnetic Knife Set with Holder is an excellent choice for home cooks who want a sleek, space-saving storage solution without sacrificing quality. This set includes six high-performance Japanese knives—ranging from a chef’s knife to a paring knife—crafted from durable 10Cr15CoMoV stainless steel with ultra-sharp 15-degree edges. The ergonomic Pakkawood handles provide comfort and control, while the magnetic acacia wood holder keeps knives organized and accessible. Dishwasher safe for convenience, this set combines style, functionality, and safety, making it ideal for those looking to elevate their kitchen tools with a modern, stylish setup.
- Blade Material:Japanese 10Cr15CoMoV high carbon stainless steel
- Cutting Edge Angle:15°
- Number of Pieces:6 pieces
- Handle Material:Pakkawood
- Storage Type:Magnetic holder
- Special Features:Hand-ground blades, magnetic holder
- Additional Feature:Natural acacia wood holder
- Additional Feature:Hand-ground 15° blades
- Additional Feature:Ergonomic Pakkawood handles
-

Huusk Butcher Knife Set of 3- Japanese Knife Set for Meat Cutting, Hand Forged Viking Knives Sets with Meat Cleaver, Heavy-Duty Kitchen Knives Sets for Bone BBQ Vegetable, Fathers' Day Gift for Dad
Versatile Chef Knife Set: This japanese kitchen knife set includes a 6.2" butcher knife for smashing bones, a...
As an affiliate, we earn on qualifying purchases.
HOSHANHO 16-Piece Japanese Kitchen Knife Set
For serious home chefs and culinary enthusiasts, the HOSHANHO 16-Piece Japanese Kitchen Knife Set offers an exceptional combination of precision, durability, and versatility. It includes a variety of expertly crafted knives—chef, bread, carving, santoku, fillet, utility, paring, and steak knives—plus a sharpening rod and kitchen shears, all stored in a ventilated knife block. The razor-sharp blades, sharpened to 15-degree angles, deliver clean, precise cuts on meat, fish, fruits, and vegetables. Made from high-quality stainless steel with a hardness of 58 HRC, these knives are resistant to stains and rust. The pakkawood handles fit comfortably, reducing fatigue during extended use.
- Blade Material:Japanese 10Cr15CoMoV stainless steel
- Cutting Edge Angle:15°
- Number of Pieces:16 pieces
- Handle Material:Pakkawood
- Storage Type:Knife block + ventilation
- Special Features:Full tang, sharpener included
- Additional Feature:Includes knife sharpener
- Additional Feature:Ventilated knife block
- Additional Feature:High-density pakkawood handles
Huusk 3-Piece Japanese Butcher Knife Set
Designed for both professional chefs and passionate home cooks, the Huusk 3-Piece Japanese Butcher Knife Set offers exceptional versatility and precision. This set includes a 6.2-inch butcher knife perfect for bone smashing, a 6.2-inch chef’s knife for chopping vegetables, and a 5.9-inch Viking knife for detailed tasks. Hand-forged from high-quality Japanese steel with traditional techniques, the blades feature a 16° razor-sharp edge for clean, precise cuts. The hand-hammered finish reduces food sticking, while the full tang steel core guarantees durability. With contoured wooden handles for comfort and control, these knives excel in both everyday cooking and professional settings.
- Blade Material:Japanese steel with high-quality forging
- Cutting Edge Angle:16°
- Number of Pieces:3 pieces
- Handle Material:Wooden (hand-polished wood)
- Storage Type:Gift box
- Special Features:Hand-forged, finger hole
- Additional Feature:Hand-forged from Japanese steel
- Additional Feature:Hand-polished wooden handles
- Additional Feature:Unique finger control hole
FULLHI 14-Piece Japanese German Stainless Steel Knife Set
If you’re serious about cooking and want a versatile, high-quality knife set that performs well both at home and outdoors, the FULLHI 14-Piece Japanese German Stainless Steel Knife Set is an excellent choice. It includes 14 carefully crafted knives, from chef and slicer to bread and santoku, plus useful accessories like finger guards, a bottle opener, and a portable sharpener. Made from high-carbon German stainless steel, the blades are ultra-sharp, durable, and resistant to stains and corrosion. The non-slip pakka wood handles offer safety and comfort, even when wet. Overall, this set combines precision, safety, and practicality for any culinary enthusiast.
- Blade Material:German 5Cr17 high-carbon stainless steel
- Cutting Edge Angle:16°
- Number of Pieces:14 pieces + accessories
- Handle Material:Pakkawood
- Storage Type:Walnut hardwood block
- Special Features:Extra accessories, ergonomic handles
- Additional Feature:Bonus safety accessories
- Additional Feature:Impact-resistant handles
- Additional Feature:Walnut hardwood storage block
Yatoshi Magnetic Japanese Knife Block Set (6 Pieces)
The Yatoshi Magnetic Japanese Knife Block Set stands out with its high-quality VG-10 core blades wrapped in 67-layer Damascus steel, ensuring exceptional durability and sharpness. The hand-shaped double-bevel blades with a 16° angle deliver precise cuts, perfect for both professional chefs and home cooks. The textured G10 handle offers a secure grip, while the concealed tang adds strength and balance. The set includes six essential knives stored in a sleek magnetic walnut wood block that keeps everything organized and accessible. Plus, the anti-skid pad prevents slipping, making this set both functional and stylish—an excellent addition to any modern kitchen.
- Blade Material:VG-10 Damascus cladding over steel core
- Cutting Edge Angle:16°
- Number of Pieces:6 pieces
- Handle Material:G10 fiberglass composite
- Storage Type:Magnetic walnut wood block
- Special Features:Damascus layered blades, anti-stick
- Additional Feature:Damascus Damascus layered blades
- Additional Feature:Concealed tang construction
- Additional Feature:Textured fiberglass G10 handles
Jikko 9-Piece Magnetic Japanese Knife Set
For home chefs who demand professional-grade performance without sacrificing style, the Jikko 9-Piece Magnetic Japanese Knife Set offers an exceptional blend of durability, sharpness, and aesthetic appeal. Crafted from premium AUS-8 steel hardened to 59 HRC, these knives stay razor-sharp up to three times longer than standard German steels. The blades feature a unique 3-phase heat treatment, forging and hammering for natural food release, and a Black Titanium-Nitride finish that resists corrosion. The set includes a versatile range of knives, reinforced with double steel for strength and weight. The magnetic olive wood block promotes airflow, keeping everything pristine, making this set both functional and elegant.
- Blade Material:AUS-8 Japanese steel with titanium finish
- Cutting Edge Angle:15°
- Number of Pieces:9 pieces + magnetic block
- Handle Material:Olive wood, resin
- Storage Type:Magnetic open-air stand
- Special Features:Open-air magnetic design, titanium coating
- Additional Feature:Limited edition design
- Additional Feature:Olive wood resin block
- Additional Feature:70-day extended warranty
SHAN ZU 7-Piece Japanese Knife Set with Block
The SHAN ZU 7-Piece Japanese Knife Set with Block stands out as an ideal choice for home chefs who prioritize sharpness, durability, and ergonomic design. It includes essential knives like an 8″ chef knife, serrated bread knife, santoku, utility, and paring knife, plus a block and sharpener. Made from high-hardness Japanese 10CR15MOV steel with a 15° cutting angle, these blades stay ultra-sharp and resistant to corrosion. The G10 fiberglass handles are ergonomic, providing a comfortable grip and reducing wrist strain. Built with a 7-layer steel structure, these knives promise long-lasting performance, backed by a lifetime guarantee and dedicated customer support.
- Blade Material:10Cr15MOV Japanese stainless steel
- Cutting Edge Angle:15°
- Number of Pieces:7 pieces + sharpener
- Handle Material:G10 fiberglass
- Storage Type:Knife block + sharpener
- Special Features:Multi-layer steel, lifetime guarantee
- Additional Feature:7-layer steel construction
- Additional Feature:Octagonal ergonomic handles
- Additional Feature:Lifetime guarantee included
14-Piece Chef Knife Set with Roll Bag
This 14-piece chef knife set with a roll bag stands out as an ideal choice for home cooks and outdoor enthusiasts who need reliable, professional-grade blades on the go. It features high-carbon stainless steel blades sharpened to 15°, perfect for precise slicing, chopping, and cutting. The pakkawood handles are durable, comfortable, and stylish in beige, making the set both functional and attractive. The included roll bag offers safe, portable storage, ideal for camping, travel, or outdoor cooking. Weighing about 3.7 pounds, it’s built for durability, rust resistance, and everyday use, making it a versatile, premium addition to any culinary adventure.
- Blade Material:Japanese high-carbon stainless steel
- Cutting Edge Angle:15°
- Number of Pieces:14 pieces + roll bag
- Handle Material:FSC-certified pakkawood
- Storage Type:Roll bag with guards
- Special Features:Portable, stylish design, high rating
- Additional Feature:Portable roll bag included
- Additional Feature:Stylish beige color
- Additional Feature:High-carbon stainless steel blades
HOSHANHO 3-Piece High Carbon Steel Kitchen Knife Set
If you’re looking for a reliable, versatile knife set that balances professional quality with everyday usability, the HOSHANHO 3-Piece High Carbon Steel Kitchen Knife Set stands out. It includes an 8-inch chef knife, a 7-inch santoku, and a 6-inch utility knife—perfect for chopping, slicing, and dicing a variety of foods. Made from Japanese 10Cr15CoMoV high carbon stainless steel, these blades are incredibly sharp, durable, and resistant to corrosion. The ergonomic pakkawood handles fit comfortably in my hand, even during extended use. Plus, the elegant gift box makes it a thoughtful choice for holidays or special occasions.
- Blade Material:10Cr15CoMoV high carbon stainless steel
- Cutting Edge Angle:15°
- Number of Pieces:3 pieces
- Handle Material:Pakkawood
- Storage Type:Gift box
- Special Features:Classic Japanese style, ergonomic handles
- Additional Feature:Elegant gift box
- Additional Feature:Hand-polished 15° blades
- Additional Feature:Classic gift presentation
HOSHANHO 7-Piece Japanese Kitchen Knife Set
For home chefs and professionals who prioritize quality, the HOSHANHO 7-Piece Japanese Kitchen Knife Set offers an excellent balance of craftsmanship and versatility. It includes a variety of knives—8 chef knives, santoku, nakiri, fillet, utility, and paring knives—plus a stylish double-sided acacia wood magnetic holder. Made from high-carbon stainless steel with vacuum heat treatment, the blades are exceptionally sharp, durable, and maintain their edge over time. The ergonomic Pakkawood handles provide comfort and stability, while the magnetic storage guarantees safety and easy access. Packaged in a beautiful gift box, it’s perfect for anyone serious about their kitchen tools.
- Blade Material:10Cr15CoMoV high-carbon stainless steel
- Cutting Edge Angle:15°
- Number of Pieces:7 pieces + magnetic holder
- Handle Material:Reinforced pakkawood
- Storage Type:Magnetic knife holder
- Special Features:Magnetic storage, comfort grip
- Additional Feature:Double-sided magnetic holder
- Additional Feature:Reinforced high-hardness handles
- Additional Feature:Beautiful gift box packaging
MITSUMOTO SAKARI 4-Piece Japanese Chef’s Knife Set
The MITSUMOTO SAKARI 4-Piece Japanese Chef’s Knife Set stands out for its traditional hand-forged craftsmanship, making it an excellent choice for both professional chefs and serious home cooks who value quality and precision. Each knife is shaped by skilled artisans through 45 days of meticulous hand forging, ensuring exceptional durability and artistry. The blades, made from three layers of top-grade 9CR18MOV high carbon steel, are ultra-thin and incredibly sharp, perfect for slicing fruits, vegetables, and meats. With ergonomic summer sourwood handles, these knives offer comfort and control. Packaged in a sleek sandalwood box, they also make a refined gift for any culinary enthusiast.
- Blade Material:9CR18MOV high carbon steel
- Cutting Edge Angle:15°
- Number of Pieces:4 pieces + box
- Handle Material:Summer sourwood wood
- Storage Type:Knife block with ventilation
- Special Features:Advanced forging, premium aesthetics
- Additional Feature:Traditional hand forging
- Additional Feature:Summer sourwood handles
- Additional Feature:45 days of forging
HOSHANHO 8-Piece Japanese Chef Knife Set with Block
The HOSHANHO 8-Piece Japanese Chef Knife Set with Block stands out as an ideal choice for home cooks and professional chefs who demand high performance and versatility in their kitchen tools. It includes essential knives—a chef, bread, santoku, fillet, utility, paring—as well as kitchen shears and a beautiful hardwood block. Crafted from high-carbon Japanese stainless steel with a 58 HRC hardness, the blades are laser-cut at a 15-degree angle for sharpness and precision. The ergonomic pakkawood handles reduce fatigue and improve control. With a sleek natural wood grain holder and a 4.7-star rating from nearly 500 reviews, this set combines durability, style, and exceptional value.
- Blade Material:10Cr15CoMoV Japanese steel
- Cutting Edge Angle:15°
- Number of Pieces:8 pieces + block
- Handle Material:Pakkawood
- Storage Type:Knife block
- Special Features:Professional quality, balanced weight
- Additional Feature:Precise laser-cut blades
- Additional Feature:Natural wood grain block
- Additional Feature:Comfortable pakkawood handles
SHAN ZU 16-Piece Japanese Kitchen Knife Set
If you’re looking for a versatile and durable knife set that covers all your kitchen needs, the SHAN ZU 16-Piece Japanese Kitchen Knife Set is an excellent choice. It includes a variety of knives like a chef, bread, carving, santoku, filleting, utility, fruit, and steak knives, plus a sharpener, scissors, and a sleek knife block. Made from high carbon Japanese steel with a 15° cutting edge, these knives deliver exceptional sharpness. The classic triple-riveted pakkawood handles and full tang construction guarantee comfort and durability. Stored neatly in the block, these stylish knives are perfect for both everyday prep and special occasions.
- Blade Material:10Cr15CoMoV Japanese steel
- Cutting Edge Angle:15°
- Number of Pieces:16 pieces + scissors/sharpener
- Handle Material:Pakkawood
- Storage Type:Knife stand + case
- Special Features:Multi-layer construction, modern aesthetic
- Additional Feature:Stylish laser-engraved blades
- Additional Feature:Full tang construction
- Additional Feature:Modern aesthetic design
SHAN ZU 16-Piece Japanese Kitchen Knife Set
For home chefs and professional cooks who demand top-tier performance, the SHAN ZU 16-Piece Japanese Kitchen Knife Set stands out with its premium materials and expert craftsmanship. Crafted from high-quality powder metallurgy steel with 63 HRC, these blades deliver three times the edge retention of standard stainless steel. The 12° double-bevel angle ensures razor-sharp, frictionless cuts, while full tang construction offers excellent balance and durability. With a sleek, modern design featuring laser-engraved patterns, stabilised wood handles, and a natural wood storage block, this set combines aesthetics with functionality. It’s perfect for tackling a wide range of culinary tasks with precision and style.
- Blade Material:Powder metallurgy steel with 63 HRC
- Cutting Edge Angle:12°
- Number of Pieces:8+ knives + accessories
- Handle Material:Stabilized wood, textured surface
- Storage Type:Wooden knife block + honing rod
- Special Features:Powder metallurgy, long-lasting edge
- Additional Feature:Powder metallurgy steel
- Additional Feature:430 steel bolsters
- Additional Feature:Textured, non-slip handles
Factors to Consider When Choosing Japanese Knife Sets

When choosing a Japanese knife set, I focus on several key factors to guarantee I get the best value and performance. I look closely at blade material quality, handle comfort, and how well the set covers my needs in variety and organization. Sharpness and storage are also essential for maintaining the knives and keeping my kitchen tidy.
Blade Material Quality
Choosing the right blade material is essential because it directly affects a knife’s performance and longevity. High-quality Japanese knives typically use high-carbon stainless steel like VG-10 or 10Cr15CoMoV, which offer excellent edge retention and corrosion resistance. The blade’s hardness, measured in HRC, usually ranges from 58 to 62, striking a balance between sharpness and durability. Multi-layer or Damascus steel blades combine softer core steel with harder outer layers, boosting strength and aesthetic appeal while resisting chipping. Precise heat treatment and cold forging are crucial for achieving the ideal hardness, flexibility, and long-lasting sharpness. The steel type and manufacturing process directly influence how well the knife maintains its edge during demanding kitchen tasks, making blade material quality a critical factor.
Handle Comfort & Grip
A comfortable and secure handle is vital for safe and precise cutting, especially during long cooking sessions. Ergonomic handles that fit well in your hand reduce fatigue and improve control. Handles made from textured materials like pakkawood or G10 offer a secure grip, even when wet, preventing slips. The shape of the handle, whether octagonal or full tang, influences balance and control, making cutting more precise. Reinforced anchor points ensure the handle remains durable and won’t loosen over time. Proper handle size and contouring are essential for maintaining safety and accuracy. When choosing a Japanese knife set, prioritize handles that feel natural in your hand, provide a firm grip, and support extended use without discomfort. Your comfort directly impacts your cutting performance.
Set Completeness & Variety
A well-rounded Japanese knife set should include a variety of blades like a chef’s knife, santoku, utility, paring, and bread knives to handle different kitchen tasks efficiently. Having multiple sizes of the same type, such as various chef knives, adds versatility for different ingredients and techniques. Including specialized knives like fillet or carving knives can expand the set’s functionality for specific culinary needs. Extras like sharpening rods, scissors, or a storage block also enhance usability and organization. I look for sets that cover all essential bases without requiring me to buy additional pieces later. A complete set simplifies my workflow and ensures I have the right tool for every task, making cooking both easier and more enjoyable.
Blade Sharpness & Edge
Blade sharpness and edge retention are key factors when selecting Japanese knife sets, as they directly impact cutting performance and ease of use. Japanese knives are typically sharpened to a 15° or lower angle, creating a thinner, sharper edge than Western knives. High-quality steels like VG-10 or 10Cr15CoMoV help the edge stay sharp longer and improve durability. Hand-ground blades with precise bevel angles contribute to ultra-sharp edges and better control. Multi-layer steel construction, such as Damascus patterns, not only looks stunning but also enhances durability while maintaining a razor-sharp edge. Regular honing and proper maintenance are essential to keep the blades performing at their best and prevent dulling over time. Sharp, well-maintained blades make all the difference in the kitchen.
Storage & Organization
When choosing a Japanese knife set, it’s vital to take into account how the knives will be stored and organized to keep them safe and accessible. I look for a dedicated storage solution like a sturdy knife block, magnetic strip, or roll-up bag that keeps knives organized and within reach. The storage material should be durable, protecting blades from damage and corrosion over time. Proper airflow and ventilation are essential to prevent moisture buildup, which can cause rust. I also check if the organization system comfortably fits all knives, with designated slots for different sizes and types. Finally, I prefer storage options that are easy to clean and maintain, ensuring hygiene and longevity for my knives.
Maintenance & Durability
Choosing the right storage solution helps protect your knives, but maintaining their sharpness and preventing damage over time is equally important. High-quality Japanese knives are crafted from high-carbon stainless steel with a hardness of 58-61 HRC, which boosts durability and edge retention. To keep them in top shape, I recommend hand washing and regular honing—these simple steps prevent corrosion and maintain sharpness. Full tang construction and handles made from materials like pakkawood or G10 add to the set’s durability and balance. Advanced forging techniques and multi-layer steel construction make these knives more resistant to chipping, cracking, and wear. Consistent sharpening, whether with a honing rod or professional service, is key to extending their lifespan and ensuring ideal performance.
Price & Brand Reputation
Reputable Japanese knife brands are essential considerations because they often guarantee higher quality materials and craftsmanship. These brands typically charge higher prices, which reflect their reputation, rigorous quality control, and customer support. Investing in a well-known brand provides peace of mind, as positive reviews and awards validate their credibility and product reliability. While budget-friendly options from lesser-known brands may seem attractive, they often cut corners on materials, sharpness, and durability, leading to lower long-term value. Choosing a reputable brand ensures you get authentic craftsmanship, access to warranties, and reliable after-sales service. Ultimately, paying a premium for a trusted name can save you money and frustration down the line, making it a smarter choice for serious chefs and home cooks alike.
Frequently Asked Questions
What Maintenance Is Required for High-Carbon Steel Japanese Knives?
High-carbon steel Japanese knives require regular maintenance to stay sharp and rust-free. I always hand wash mine immediately after use, avoiding dishwasher damage. I dry them thoroughly and occasionally apply a light coat of oil to prevent corrosion. Sharpening is essential—using a whetstone guarantees they stay razor-sharp. With proper care, these knives will perform beautifully and last for years, maintaining their edge and appearance.
Are Japanese Knife Sets Suitable for Beginner Home Cooks?
Absolutely, Japanese knife sets are great for beginners! I was hesitant at first, but I found that their sharpness and precision make cooking easier. They’re usually lightweight and well-balanced, which helps new cooks feel confident handling them. Just remember to learn proper techniques and maintenance, like regular honing and careful cleaning. With a little practice, you’ll find these knives become your go-to tools in the kitchen!
How Do I Choose the Right Size and Weight for My Knives?
I recommend choosing a knife size between 6 to 8 inches, as it’s versatile and comfortable for most tasks. For weight, go for a balanced feel—neither too heavy nor too light—so you can control it easily without fatigue. I suggest handling a few knives in-store if possible, to see what feels best in your hand. Ultimately, the right size and weight depend on your comfort and the tasks you’ll perform most often.
What Are the Differences Between Stainless Steel and Carbon Steel Japanese Knives?
Stainless steel Japanese knives are more durable, resistant to rust, and require less maintenance, making them perfect for everyday use. Carbon steel knives, on the other hand, are sharper and easier to sharpen, offering exceptional precision, but they rust easily and need regular care. I prefer stainless for convenience, but if you’re a professional or serious home cook, carbon steel can give you that razor edge you crave.
Can Japanese Knife Sets Be Used for Professional Culinary Purposes?
Yes, Japanese knife sets are perfect for professional culinary use. I’ve used them in busy kitchens, and their sharpness and precision make chopping, slicing, and dicing effortless. Chefs love their lightweight design and excellent balance, which reduces fatigue during long shifts. Just keep them properly maintained and sharpened, and these knives can handle all the demanding tasks in a professional setting, delivering first-rate results every time.
Conclusion
After exploring these top Japanese knife sets, I believe the right choice really depends on your cooking style and needs. It’s like finding the perfect tool that makes prep work feel effortless. Japanese knives are celebrated for their sharpness and craftsmanship, so I’d say trust your instincts and consider factors like set size and handle comfort. Ultimately, a quality Japanese knife set can elevate your culinary game—so choose what feels right for you!